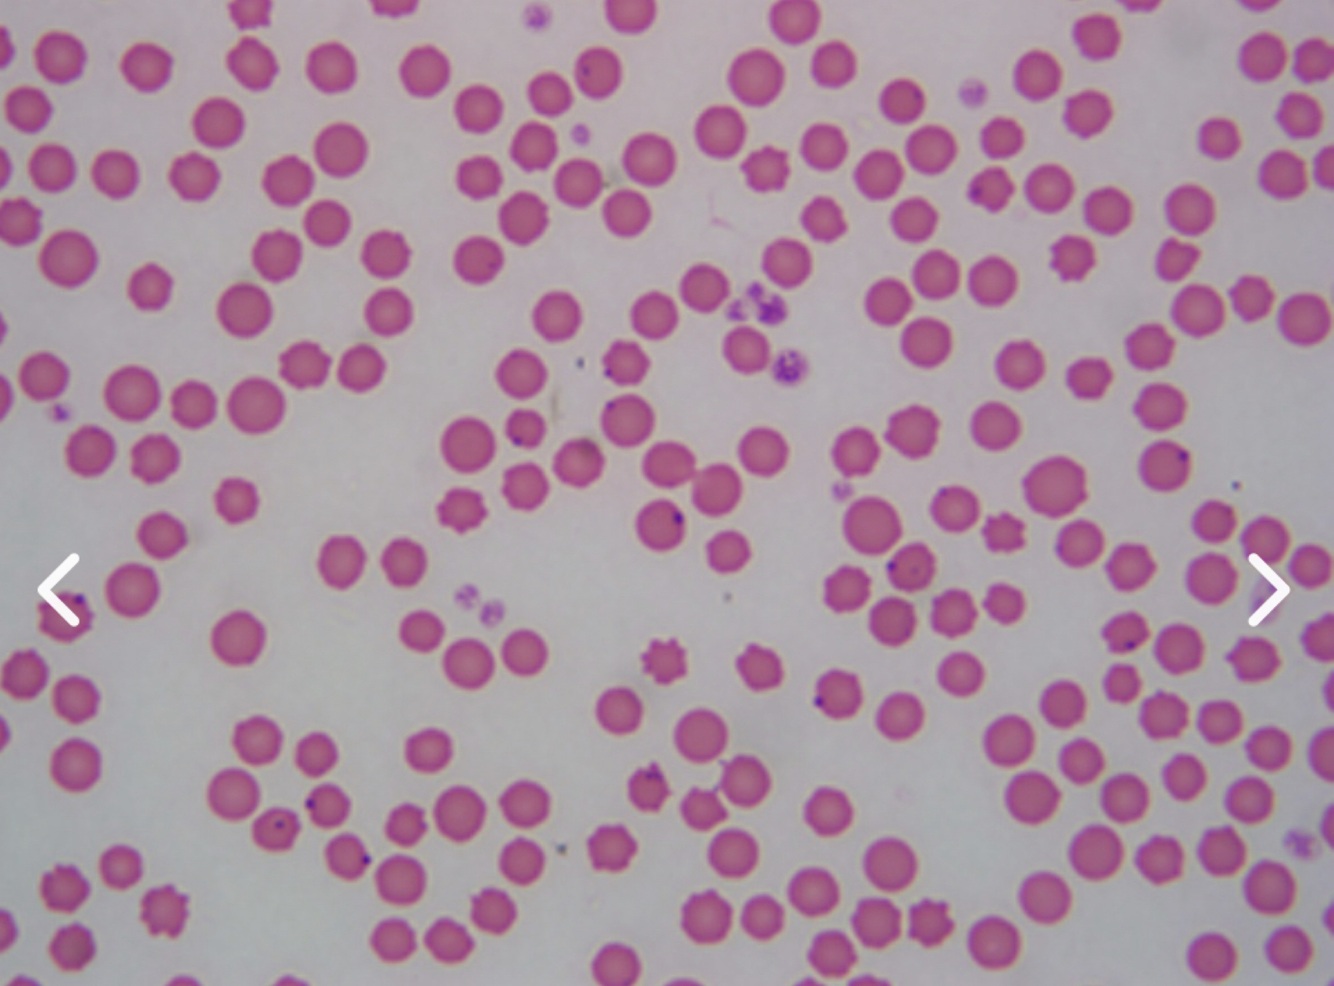
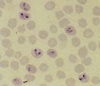

You are called out to a dairy herd that has recently been experiencing reproductive problems. The cows were all acquired 1 year ago from an unknown source and have no known vaccinations or tattoos. The dairyman reports that several cows have had late abortions (6-7 months gestation) and weak or stillborn calves in the past year and he’s never had this problem before. Several of the cows that had abortions developed placental retention and/or metritis.
None of the younger pre-pubescent heifers are displaying any clinical signs. You perform a necropsy on two recently aborted fetuses and find lung consolidation in one but no other obvious abnormalities. Which of the following should you recommend?
- Serologic testing for Neospora
- Test for Trichomoniasis
- Test for Campylobacter fetus subsp venerealis
- Serologic testing for Brucellosis
Answer: Serologic testing for Brucellosis
Explanation
You should be most suspicious of Brucellosis based on the assortment of signs (abortions, retained placenta, metritis and lack of signs in younger animals), the timing of abortions (last half of pregnancy), and the relatively normal appearance of the examined fetuses. Plus the cattle are not tattooed as they should be if they were given calfhood brucella vaccine.
Tritrichomonas fetus abortions usually occur in the first half of gestation but do have placentitis and pneumonia in the fetus as does Brucella.
Campylobacter fetus subsp venerealis usually causes early embryonic death.
Neospora abortions are usually mid gestation and cause necrosis of the cotyledons, with fetal lesions including myocarditis, hepatitis, myositis and encephalitis.
When performing a necropsy on a cow, you find multiple abnormalities including abomasal ulcers, interstitial pneumonia, pericardial effusion, and mastitis. You also see that the liver has a brown- (tan) and red-mottled lobular pattern described as a nutmeg liver. Which of these conditions in the cow could lead to the necropsy findings in the liver?
- Pericardial effusion
- Abomasal ulcers
- Interstitial pneumonia
- Mastitis
Answer: Pericardial effusion.
Explanation
The appearance of a nutmeg liver occurs because there are red central veins and sinusoids between tan areas of swollen hepatocytes. This occurs with right sided heart failure from passive congestion of the sinusoids of hepatocellular hypoxia. Pericardial effusion causes right sided heart failure and is the cause of the liver’s appearance.
You perform a joint tap on a swollen carpus of this bull in the picture and obtain the following results: total protein 4.7 g/dl, total nucleated cell count 26,900/ul, 84% neutrophils. What is your interpretation of these results?
- Normal
- Unlikely to be infected
- Likely to be immune mediated joint disease
- Likely infected

Answer: Likely infected.
Explanation
The correct answer is likely infected.
Guidelines for an infected joint are as follows:
- total protein greater than 4.5 g/di
- total nucleated count greater than 25,000/ul
- polymorphonuclear cell count greater than 20,000/ul
A group of yearling steers were recently fed moldy sweet potatoes two days ago. Yesterday, they began to exhibit tachypnea, dyspnea, grunting, frothing at the mouth, deep cough, and respiratory distress. Today there are several dead. The lungs are wet, firm, and fail to collapse. Lobules are dark red and firm, with hemorrhages, edema, emphysema and bullae throughout the interstitial pneumonia. What is the cause of this disorder?
- 4-ipomeanol
- Bovine virus diarrhea
- 3-methylindole
- Mannheimia hemolytica
- Bovine respiratory syncytial virus
Answer: 4-ipomeanol
Explanation
A metabolite of 4-ipomeanol is a pneumotoxic compound that is produced by the fungus Fusarium solani acting on the sweet potato compound called 4-hydroxymyoporone. This metabolite is toxic to pulmonary tissues. Lesions are similar to those found with acute bovine pulmonary edema and emphysema (ABPE) caused by conversion of ingested L-tryptophan in lush pastures to pneumotoxic 3-methylindole.
The disorder in the steers is caused by 4-ipomeanol, a pneumotoxic compound produced by Fusarium solani acting on sweet potato 4-hydroxymyoporone. This toxin affects pulmonary tissues, causing lesions like those in acute bovine pulmonary edema and emphysema (ABPE) from L-tryptophan conversion to 3-methylindole in lush pastures. Symptoms include respiratory distress and lung pathology.
CGPT: 4-Ipomeanol Toxicosis (Moldy Sweet Potato) and Perilla Ketone Toxicosis (Purple Mint Toxicosis) in Cattle
Definitions and Causative Agents:
• 4-Ipomeanol Toxicosis: Caused by ingestion of moldy sweet potatoes infested with Fusarium solani, producing the pneumotoxin 4-ipomeanol. • Perilla Ketone Toxicosis: Caused by ingestion of leaves and seeds of Perilla frutescens (purple mint), containing a pneumotoxin.
Clinical Changes and Symptoms:
• Similar to acute bovine pulmonary emphysema and edema (ABPEE). • Symptoms: Severe dyspnea, frothy nasal discharge, coughing, tachypnea, and death in severe cases.
Diagnosis:
• Tests: History of ingestion, clinical signs, necropsy findings. • Findings: Pulmonary edema, emphysema.
Treatment:
• Medications: • Corticosteroids: Dexamethasone to reduce inflammation. • Diuretics: Furosemide to manage pulmonary edema. • Supportive Care: Oxygen therapy, maintaining hydration.
Prevention:
• Avoid feeding moldy sweet potatoes or exposure to purple mint.

A clinician calls you about a heifer he examined and mentions that he heard a murmur over what he thought was the aortic region. Over which intercostal space would an aortic valve murmur be heard best?
- Left 3rd intercostal space
- Right 3rd intercostal space
- Left 4th intercostal space
- Right 4th intercostal space
- Left 5th intercostal space
Answer: Left 4th intercostal space
Explanation
The correct answer is the left 4th intercostal space. We at VetPrep always think of our left-handed ex-girlfriend PAM. That stands for Pulmonic, Aortic and Mitral and then you just work your way from the 3rd intercostal space (pulmonic) to the 5th intercostal space (mitral). So the point of maximal intensity for an aortic murmur will be on the 4th intercostal space. Keep in mind that this is all on the left side. On the right side the only valve you can appreciate is the tricuspid valve which is audible best between the 3rd and 4th intercostal space.
The aortic valve murmur is best heard at the left 4th intercostal space. Remember “PAM” (Pulmonic, Aortic, Mitral), moving from the 3rd (pulmonic) to the 5th (mitral) intercostal space on the left side. The tricuspid valve is heard on the right side between the 3rd and 4th intercostal spaces.
A cow presents to you for decreased milk production. On physical exam, you determine the cow has a much stronger pulse on expiration than she does on inspiration. What is this pulse associated with?
- Pericardial effusion
- Atrial premature contractions
- Patent ductus arteriosus
- Atrial fibrillation
Answer: Pericardial effusion
Explanation
The correct answer is pericardial effusion. Pulsus paradoxus is an exaggeration of normal variations in the pulse quality during the respiratory cycle; the pulse becomes weaker on inhalation and stronger on exhalation. It is characteristic of constrictive pericarditis or pericardial effusion. Atrial premature contractions are more likely to result in pulse deficits.
Atrial fibrillation is likely to result in pulsus alternans, in which you see two quick normal pulses in a row followed by no pulse.
A patent ductus arteriosus usually is found only in very young animals and results in waterhammer pulses which is a large bounding pulse with a sharp peak and very rapid decline.
Pericardial effusion is associated with a stronger pulse on expiration than on inspiration, known as pulsus paradoxus. This exaggerated variation in pulse quality during the respiratory cycle is characteristic of pericardial effusion or constrictive pericarditis. In contrast, atrial premature contractions cause pulse deficits, and atrial fibrillation leads to pulsus alternans.
A very valuable dairy cow has died after a long illness with fever that the owner had treated with potent antimicrobial drugs for a week, then had given up. He asks you to perform a post-mortem to tell him the cause of death so he can collect insurance money. You find edematous lungs, edema in the ventral thoracic subcutaneous tissues, and this heart lesion. What is the diagnosis?
- Valvular endocarditis
- Pulmonary stenosis
- White muscle disease
- Tetralogy of Fallot
- Ventricular septal defect

Answer: Valvular endocarditis
Explanation
Bacteria can lodge on heart valves and collect platelets and do damage to valves, causing murmurs and dysfunction and in some cases heart failure. The bacteria usually enter via a septic site such as a hoof abscess.
Valuable cows should be treated with penicillin or ceftiofur for several days if they develop hoof abscesses or similar problem.
The diagnosis is valvular endocarditis. Bacteria from a septic site, such as a hoof abscess, can lodge on heart valves, causing damage, murmurs, and potential heart failure. Valvular endocarditis is associated with edematous lungs and subcutaneous edema. Treatment for valuable cows with hoof abscesses includes penicillin or ceftiofur for several days.
What cardiac abnormality is commonly associated with hypocalcemia and milk fever in the cow?
Tachycardia
Atrial fibrillation
Ventricular premature contractions
Sinoatrial node block
Answer: Tachycardia
Explanation
The correct answer is tachycardia. Calcium administration may cause all the other abnormalities if you give too much too fast. You may also see a sinus node arrest. Calcium administration will cause the heart to beat more slowly and more strongly.
The cardiac abnormality commonly associated with hypocalcemia and milk fever in cows is tachycardia. Rapid calcium administration can cause other abnormalities, such as ventricular premature contractions, sinoatrial node block, or sinus node arrest, leading to a slower and stronger heartbeat.
Parturient Paresis in Cows - Comprehensive Information
Definitions and Causative Agents:
• Parturient Paresis (Milk Fever): Acute hypocalcemia causing flaccid paralysis around parturition. • Causative Agents: Low blood calcium due to high calcium demand at lactation onset.
Clinical Findings:
• Stage 1: Hyperexcitability, ataxia, tremors. • Stage 2: Sternal recumbency, cold extremities, tachycardia, dry muzzle. • Stage 3: Lateral recumbency, coma, severe muscle flaccidity, potential death.
Diagnosis:
• Clinical Signs: Recumbency, muscle tremors, decreased heart sounds. • Blood Tests: Hypocalcemia confirmation.
Treatment:
• Stage 1: Oral calcium supplements (40-55 g elemental calcium). • Stage 2 & 3: IV calcium gluconate (500 mL of 23% solution), slow infusion.
Prevention:
• Dietary Management: Acidogenic diets prepartum (DCAD of -50 to -150 meq/kg). • Monitoring: Urinary pH to maintain optimal acidification. • Prophylactic Calcium: Oral calcium around calving.
A rancher has just found a big 2 month-old calf dead in the field and asks you to perform a post-mortem to determine the cause of death. He is worried about a contagious disease in his herd. You find the lungs are edematous and there is mild bronchopneumonia, but this lesion is found in the heart. Which diagnosis best fits?
Pulmonary stenosis
Tetralogy of Fallot
Ventricular septal defect
Patent ductus arteriosus
Bacterial endocarditis

Answer: Ventricular Septal Defect
Explanation
Congenital ventricular septal defect is one of the most commonly encountered congenital cardiac defects in cattle. It may be a relatively benign of cause death, depending on size. If the rancher sees several calves with this defect, he should discontinue using the bull responsible.
The diagnosis is ventricular septal defect, a common congenital cardiac defect in cattle. Its severity can vary, sometimes leading to death. If multiple calves are affected, the rancher should stop using the responsible bull to prevent further cases. Other diagnoses are less likely based on the findings.
A 7 year old Jersey cow presents to you with anorexia, bottle jaw, brisket edema, and a true jugular pulse. She has a heart rate of 90 bpm, rapid respiration, and is depressed. What is your primary differential?
Generalized lymphangitis
Right heart failure
Salt poisoning
Anaplasmosis
Answer: Right heart failure
Explanation
The correct answer is right heart failure. As a result of an inability to pump blood, it backs up and edema and a true jugular pulse occur.
The primary differential is right heart failure. The inability of the heart to pump blood effectively leads to backup, resulting in edema, bottle jaw, brisket edema, and a true jugular pulse. This is consistent with the cow’s clinical signs.
What is the most common supraventricular arrhythmia in cattle?
Atrial fibrillation
Ventricular fibrillation
Sinoatrial node arrest
Atrial standstill
Answer: Atrial fibrillation
Explanation
The correct answer is atrial fibrillation. This usually occurs as a result of digestive disturbances. It is associated with vagal tone, hypokalemia, hyperkalemia, and calcium therapy. You may be able to palpate a pulse deficit and/or pulsus alternans in these animals. On ECG, there will be no P waves because the sinoatrial node is not working. You will see random high frequency, low amplitude depolarizations called F waves. A QRS wave that occurs at irregular intervals will be present.
The most common supraventricular arrhythmia in cattle is atrial fibrillation, often resulting from digestive disturbances. It is linked to vagal tone, electrolyte imbalances, and calcium therapy. On ECG, there are no P waves, with irregular QRS waves and F waves due to sinoatrial node dysfunction.
You are in the process of performing an ECG on a Charolais cow with chronic pulmonary disease and notice that the P wave is tall and slender and measures 0.48mV (normal <0.4 mV), a condition known as P pulmonale. What conclusion as to the nature of the cardiac abnormality can you make from this finding?
Left atrial enlargement
Right atrial enlargement
Congestive heart failure
Left ventricular enlargement
Answer: Right atrial enlargement
Explanation
The correct answer is right atrial enlargement. This ECG finding is known as P pulmonale and is characterized by tall slender peaked P waves greater than 0.4mV. Many times these patients have a history of chronic pulmonary disease.
Left atrial enlargement on an ECG is known as P mitrale. In this case, an increase in duration of the P wave is seen. Usually they will last at least 0.05 seconds. The reason you see these electrical changes is because of the resulting vectors that are produced by having a certain portion of the heart enlarged.
The conclusion is right atrial enlargement, indicated by the P pulmonale finding on the ECG, characterized by tall, slender P waves over 0.4mV. This is commonly seen in patients with chronic pulmonary disease. Left atrial enlargement, or P mitrale, shows prolonged P wave duration instead of increased height.
A rancher who lives at 8000 ft. elevation in Colorado is planning to buy good bulls and wants you to test them for susceptibility to high mountain disease (pulmonary hypertension and cor pulmonale). See image for what high mountain disease looks like. You recommend doing pulmonary artery pressure (PAP) testing in the squeeze chute to measure their susceptibility to pulmonary hypertension. Which of the following PAP measurements, taken at 6000 ft. elevation, would be satisfactory for this ranch to purchase?
- 45 to 50 mmHg pressure
- None, the testing must be done below 5000 ft. elevation to be reliable
- None, there is no reliable way to predict susceptibility to high mountain disease
- Less than 40 mmHg pressure
- 55 to 60 mmHg pressure

Answer: Less than 40mmHg pressure
Explanation
PAP testing done at elevations 6000 ft. or above on animals over 12 months of age is a reliable predictor of genetic susceptibility to high mountain disease (the BMPR gene is involved). The lowest pulmonary artery pressure readings are the least susceptible animals. Using local anesthesia, a catheter is inserted into the jugular vein and threaded into the right heart and pulmonary artery where the pressure is taken while the animal is restrained in a squeeze chute. The condition is caused by a genetic predisposition to developing pulmonary hypertension when oxygen tension is reduced.
The pulmonary hypertension leads to pulmonary artery hypertrophy, cor pulmonale, and right heart failure. The hallmarks are lethargy, distended jugular vein, and ventral edema (see image), as well as diarrhea, pulmonary edema, and pleural effusion.
Ingestion of toxic plants such as locoweed worsen the disease by causing additional pathology.
Cold weather, pregnancy and other stresses can also predispose animals and cause borderline susceptible animals to develop the condition.
A satisfactory pulmonary artery pressure (PAP) measurement for bulls at 6000 ft. elevation to predict susceptibility to high mountain disease is less than 40 mmHg. PAP testing at elevations of 6000 ft. or above is reliable for detecting genetic susceptibility. Animals with lower pressures are less likely to develop pulmonary hypertension, cor pulmonale, and right heart failure.
Bovine High-Mountain Disease (BHMD): NAVLE Study Guide
Definitions and Etiology
• BHMD: Also known as “Brisket Disease,” it occurs in cattle at high altitudes due to hypoxia-induced pulmonary hypertension.
• Causative Factors: Genetic predisposition, high altitude, pulmonary vascular shunting, and locoweed poisoning (Oxytropis and Astragalus spp.).
Pathophysiology
• Mechanism: Hypoxia causes pulmonary arterial vasoconstriction and hypertrophy, leading to pulmonary hypertension, right ventricular hypertrophy, and eventual congestive heart failure.
• Vascular Remodeling: Chronic exposure results in loss of peripheral pulmonary arteries and increased pulmonary resistance.
Clinical Signs
• Symptoms: Brisket edema, pleural effusion, jugular distension, cyanosis, labored breathing, and sometimes exophthalmos. Animals may become recumbent and show signs of right heart failure.
• Advanced Signs: Ascites, profuse diarrhea, and decreased appetite due to intestinal venous hypertension.
Diagnosis
• Pulmonary Arterial Pressure (PAP): Elevated PAP (>50 mmHg) and visible signs of right ventricular failure. Radiographic and ultrasonographic findings support the diagnosis.
• Differential Diagnosis: Includes other causes of congestive heart failure, such as pericarditis, lymphosarcoma, and myocarditis.
Treatment
• Primary Treatment: Moving affected cattle to lower altitudes, supportive care, diuretics, and thoracocentesis. Affected cattle should not be returned to high altitudes.
• Prevention: Selective breeding for animals with lower PAP measurements, minimizing exposure to locoweed, and addressing concurrent diseases.
Key Points for Veterinary Professionals
• Genetic Selection: Breeding programs should focus on selecting cattle resistant to hypoxia.
• Environmental Management: Control exposure to high-altitude stressors and toxic plants like locoweed.
• Ongoing Research: Studies on genetic markers and improving diagnostic techniques for BHMD are critical for future prevention and management strategies.
In this type of arrhythmia, the P-R interval progressively gets larger until there is a dropped QRS complex (P wave without a QRS complex).
First degree heart block
Third degree heart block
Second degree Mobitz type I heart block
Second degree Mobitz type Il heart block
Answer: Second degree Mobitz type I heart block
Explanation
The correct answer is Second degree Mobitz type I heart block, also known as the Wenckebach beat. In a Mobitz type Il block, the P-R interval duration is unchanged and occasionally you will observe a P wave without a QRS complex. These blocks are thought to be caused by a refractory AV node which is not responding to a delayed atrial depolarization. In a 1st degree heart block, you will observe an increased P-R interval and no dropped QRS. In 3rd degree heart blocks, the P waves are unassociated from the QRS complex.
The arrhythmia described is a Second degree Mobitz type I heart block (Wenckebach beat), where the P-R interval progressively lengthens until a QRS complex is dropped. In contrast, Mobitz type II shows no P-R interval change but occasional dropped QRS complexes. First-degree heart block has an increased P-R interval without dropped QRS, and third-degree heart blocks show no association between P waves and QRS complexes.
A cow presents due to a decrease in milk production. On physical exam, you were unable to hear the heart clearly (it is muffled). You decide to perform an ECG and immediately recognize that this cow has electrical alternans. What is most likely to be occurring?
Right atrial enlargement
Pericardial effusion
Left ventricular enlargement
Right ventricular enlargement
Left atrial enlargement
Answer: Pericardial effusion
Explanation
The correct answer is pericardial effusion. Electrical alternans is a classic finding in cases where there is pericardial effusion. Electrical alternans is characterized by different amplitudes of multiple successive R waves in the QRS complex. This is thought to be a result of the heart shifting around within the fluid filled compartment of the pericardial sac.
The most likely condition is pericardial effusion. Electrical alternans, seen as varying R wave amplitudes in the QRS complex, is a classic sign of pericardial effusion. This occurs due to the heart shifting within the fluid-filled pericardial sac, leading to muffled heart sounds.
A 3-year old Jersey heifer is not doing well and is euthanized with a post-mortem performed in the field. Below is an image of her heart, with the right atrium and right ventricle opened. What is your diagnosis?
Tricuspid valve endocarditis
Ventricular septal defect
Cardiac neoplasia
No significant findings
Tricuspid valve dysplasia

Answer: Tricuspid valve endocarditis
Explanation
The correct answer is tricuspid valve endocarditis. Hemorrhagic and white masses are seen on all leaflets of the tricuspid valve which makes endocarditis the most likely diagnosis in a young heifer. Neoplasia is unlikely on the valve and at this age; tricuspid valve dysplasia would be seen as short, thick chordae but no masses; a VSD would be seen as a hole between the right and left ventricle which is not apparent here.
The diagnosis is tricuspid valve endocarditis. Hemorrhagic and white masses on all tricuspid valve leaflets are indicative of endocarditis, especially in a young heifer. Neoplasia is unlikely at this age and location. Tricuspid valve dysplasia would show thickened chordae without masses, and a ventricular septal defect would appear as a hole between ventricles, which is not present here.
Bovine Cardiac Diseases Overview:
• Cardiac diseases in bovine primarily affect the pericardium, myocardium, and endocardium. Congenital heart diseases, such as ventricular septal defects, are also noted but rare.
Pericardial Diseases:
• Common Diseases: Traumatic pericarditis, pericarditis secondary to pleural or lung infections, neoplastic effusions due to lymphoma or mesothelioma, and idiopathic aseptic pericarditis.
• Pathophysiology: Inflammation of the pericardium due to trauma or infection leads to the accumulation of serous or fibrinous products. The proximity of the reticulum to the pericardium in cattle increases the risk of traumatic pericarditis, particularly due to hardware disease.
• Symptoms: Tachycardia, muffled heart sounds, jugular vein distension, ventral edema, anorexia, decreased milk production, and pyrexia. In advanced cases, there may be diarrhea, congested mucous membranes, and increased capillary refill time.
• Diagnostics: Clinical signs, radiographic findings (enlarged cardiac silhouette), ultrasonography, echocardiography (gold standard), and electrocardiography (base-apex lead system).
• Treatment: Digoxin to improve venous return and reduce afterload, antibiotics like amoxicillin or aminoglycosides, pericardiocentesis for fluid drainage, and in severe cases, surgical pericardiotomy or pericardiectomy.
• Prognosis: Generally poor, with treatments aimed at short-term survival for calving or superovulation.
Myocardial Diseases:
• Common Diseases: Dilated cardiomyopathy (DCM) is the most common myocardial disease in cattle, often affecting Holstein-Friesian cattle due to possible genetic factors.
• Pathophysiology: DCM involves myocardial dysfunction due to various etiologies, including immune dysfunction, viral infections, and genetic predispositions. Other causes include toxic effects from ionophores or selenium deficiency.
• Symptoms: Subcutaneous edema, jugular vein distension, ascites, heart murmurs, diarrhea, and muffled heart sounds.
• Diagnostics: Clinical signs, echocardiography, and biochemical analysis (elevated liver enzymes, creatinine, and transferrin).
• Treatment: No specific treatment for DCM. Supportive care includes correcting electrolyte imbalances and treating underlying causes.
• Prognosis: Fatal in primary DCM; prognosis improves with early detection and resolution of secondary causes.
Endocardial Diseases:
• Common Diseases: Bacterial endocarditis, often secondary to chronic infections (e.g., mastitis, metritis, or abscesses).
• Pathophysiology: Persistent bacteremia leads to endocardial infection, with common bacteria being Arcanobacterium pyogenes and streptococci.
• Symptoms: Weight loss, decreased milk production, tachycardia, murmurs, jugular distension, fever, and edema.
• Diagnostics: Hematological findings (anemia, leukocytosis), echocardiography (vegetative lesions), and blood cultures.
• Treatment: Long-term antibiotic therapy (minimum of four weeks) to arrest valve destruction and eliminate sepsis.
• Prognosis: Dependent on early diagnosis; prognosis worsens with delayed treatment.
Congenital Heart Diseases:
• Common Conditions: Ventricular septal defects, atrial septal defects, and patent ductus arteriosus.
• Symptoms: Ill-thrift, poor growth, respiratory disease, and sudden death.
• Diagnostics: Echocardiography and radiography for assessing congenital defects.
• Treatment: No surgical or medicinal treatments available for congenital heart disease in cattle.
• Prognosis: Varies from guarded to poor.
Cardiac Neoplasia:
• Common Tumors: Lymphoma is the most common, along with others like hemangiosarcoma, fibrosarcoma, and mesothelioma.
• Symptoms: Similar to pericarditis or congestive heart failure, with additional signs of neoplasia like lymphadenopathy.
• Diagnostics: Peripheral lymph node aspirates, echocardiography, and pericardiocentesis.
• Treatment: Palliative treatments like thoracoscopic pericardiotomy or repeated pericardiocentesis; antibiotics and diuretics for symptom management.
• Prognosis: Generally poor, with short-term survival following palliative care.
Congestive Heart Failure (CHF):
• Pathophysiology: Result of progressive heart disease leading to fluid retention and edema.
• Symptoms: Syncope, exercise intolerance, weakness, effusion, and edema.
• Diagnostics: Clinical signs, echocardiography, and blood gas analysis.
• Treatment: Digoxin for initial therapy, potassium supplementation, and cautious use of furosemide to resolve edema.
• Prognosis: Short-term improvement possible with medicinal therapy; long-term outcomes are generally poor.
https://www.researchgate.net/profile/Ashwani-Kumar-54/publication/336121748_An_overview_on_the_diagnostic_and_therapeutic_aspects_of_cardiac_diseases_in_bovine/links/5d8f9b26299bf10cff17f7b4/An-overview-on-the-diagnostic-and-therapeutic-aspects-of-cardiac-diseases-in-bovine.pdf
This 3 1/2 month old calf presents for weakness and failure to thrive. On physical exam you find normal temperature but rapid heart and respiratory rates. A loud holosystolic murmur is heard on both sides of the thorax with maximal intensity in the region of the tricuspid valve. It is also clearly heard on the left side with maximal intensity near the pulmonic valve (far forward). What is the most likely diagnosis?
Endocarditis
Ventricular septal defect
Patent ductus arteriosus
Patent foramen ovale
Traumatic reticulopericarditis

Answer: Ventricular septal defect
Explanation
The correct answer is ventricular septal defect. In order to answer this question, you need to “play the odds” and know that VSDs are the most common congenital heart defect in cattle, and they usually present at about 2-3 months of age because they are failing to thrive and/or are developing pulmonary edema and secondary pneumonia. This defect results in oxygenated blood being pushed back into the right atrium and ventricle. In addition, you will see right ventricular dilation and hypertrophy. The increased flow through the right side creates a relative pulmonic stenosis, and thus the murmur is also heard on the left side in the area of the pulmonic valve. VSD is the most common congenital defect in cattle.
The most likely diagnosis is a ventricular septal defect (VSD). VSDs are the most common congenital heart defect in cattle, usually presenting at 2-3 months of age with failure to thrive. The defect causes oxygenated blood to flow back into the right atrium and ventricle, leading to right ventricular dilation, hypertrophy, and a murmur heard on both sides of the thorax.
Which of the following is not a feature of Tetralogy of Fallot?
Pulmonic valve stenosis
Aortic valve stenosis
Ventricular septal defect
Right ventricular hypertrophy
Dextropositioned aorta
Answer: Aortic Valve Stenosis
Explanation
The correct answer is aortic valve stenosis. Excellent job if you remembered this one! In case you don’t remember the four features of Tetralogy of Fallot, they are: Right ventricular hypertrophy, ventricular septal defect, dextropositioned aorta (over-riding aorta), and pulmonic valve stenosis. Clinical signs include a bilateral basilar murmur, right sided heart failure, cyanosis, and secondary bacterial endocarditis.
***PowerLecture: Cardiology Disease Specific Pearls of Wisdom
* Tetralogy of Fallot in Animals
Definition:
• Congenital heart defect with four components: pulmonic stenosis, ventricular septal defect, right ventricular hypertrophy, and overriding aorta.
Affected Species:
• Dogs (e.g., Keeshonds, English Bulldogs), cats.
Clinical Signs:
• Cyanosis, exercise intolerance, stunted growth, collapse, seizures. • Loud ejection heart murmur, precordial thrill.
Diagnosis:
• Echocardiography: Confirms structural defects. • Radiographs: Right heart enlargement. • ECG: Right ventricular enlargement.
Treatment:
• Beta-adrenergic blockers to manage outflow obstruction. • Periodic phlebotomy for polycythemia. • Surgical options: Palliative techniques, valvuloplasty.
Control:
• Manage based on severity, supportive care, and specific surgical interventions.
While performing a physical exam on a cow, you notice a rapid irregular heart rate with no atrial sounds or compensatory pauses. There is no regular rhythm to the irregularity. What is this?
Sinus arrhythmia
Ventricular tachycardia
Bradyarrhythmia
Atrial fibrillation
Answer: Atrial fibrillation
Explanation
This is descriptive for atrial fibrillation. If you ran an ECG, you would find no P waves and variable intervals between QRS complexes. Atrial fibrillation is the most common arrhythmia in cattle, often due to Gl or electrolyte abnormalities.
The condition described is atrial fibrillation. It presents as a rapid, irregular heart rate without atrial sounds or compensatory pauses, and an irregular rhythm. On ECG, you’d find no P waves and variable intervals between QRS complexes. Atrial fibrillation is common in cattle, often linked to GI or electrolyte abnormalities.
You examine a valuable beef bull that was recently purchased in Texas and taken to the mountains of Colorado. The pasture is a mountain meadow at 10,000 feet elevation. The bull has developed edema of the brisket and ventral thorax, submandibular edema, dyspnea and tachypnea. Rectal temperature is normal. The HR is 90, and heart sounds are clearly audible without murmurs. What is your diagnosis?
Ventricular septal defect
Valvular endocarditis
Cardiomyopathy
High mountain disease
Traumatic pericarditis
Answer: High mountain disease
Explanation
The key to this question is the altitude mentioned in the question and accompanying clinical signs. Also called brisket disease and high altitude disease, this condition can be fatal and is brought on by elevations above 6000 feet. Hypoxic vasoconstriction (worse in some lines of cattle) causes pulmonary hypertension, which leads to cor pulmonale, which is secondary cardiac disease including right heart enlargement and failure.
The diagnosis is high mountain disease, also known as brisket disease or high altitude disease. This condition occurs at elevations above 6000 feet, causing hypoxic vasoconstriction, leading to pulmonary hypertension, cor pulmonale, right heart enlargement, and failure. The clinical signs include brisket edema, submandibular edema, dyspnea, and tachypnea, with normal rectal temperature and clear heart sounds.
Bovine High-Mountain Disease (BHMD): NAVLE Study Guide
Definitions and Etiology
• BHMD: Also known as “Brisket Disease,” it occurs in cattle at high altitudes due to hypoxia-induced pulmonary hypertension.
• Causative Factors: Genetic predisposition, high altitude, pulmonary vascular shunting, and locoweed poisoning (Oxytropis and Astragalus spp.).
Pathophysiology
• Mechanism: Hypoxia causes pulmonary arterial vasoconstriction and hypertrophy, leading to pulmonary hypertension, right ventricular hypertrophy, and eventual congestive heart failure.
• Vascular Remodeling: Chronic exposure results in loss of peripheral pulmonary arteries and increased pulmonary resistance.
Clinical Signs
• Symptoms: Brisket edema, pleural effusion, jugular distension, cyanosis, labored breathing, and sometimes exophthalmos. Animals may become recumbent and show signs of right heart failure.
• Advanced Signs: Ascites, profuse diarrhea, and decreased appetite due to intestinal venous hypertension.
Diagnosis
• Pulmonary Arterial Pressure (PAP): Elevated PAP (>50 mmHg) and visible signs of right ventricular failure. Radiographic and ultrasonographic findings support the diagnosis.
• Differential Diagnosis: Includes other causes of congestive heart failure, such as pericarditis, lymphosarcoma, and myocarditis.
Treatment
• Primary Treatment: Moving affected cattle to lower altitudes, supportive care, diuretics, and thoracocentesis. Affected cattle should not be returned to high altitudes. • Prevention: Selective breeding for animals with lower PAP measurements, minimizing exposure to locoweed, and addressing concurrent diseases.
Key Points for Veterinary Professionals
• Genetic Selection: Breeding programs should focus on selecting cattle resistant to hypoxia.
• Environmental Management: Control exposure to high-altitude stressors and toxic plants like locoweed.
• Ongoing Research: Studies on genetic markers and improving diagnostic techniques for BHMD are critical for future prevention and management strategies.
When performing a necropsy on a cow, you find multiple abnormalities including abomasal ulcers, interstitial pneumonia, pericardial effusion, and mastitis. You also see that the liver has a brown- (tan) and red-mottled lobular pattern described as a nutmeg liver. Which of these conditions in the cow could lead to the necropsy findings in the liver?
Pericardial effusion
Abomasal ulcers
Interstitial pneumonia
Mastitis
Answer: Pericardial effusion
Explanation
The appearance of a nutmeg liver occurs because there are red central veins and sinusoids between tan areas of swollen hepatocytes. This occurs with right sided heart failure from passive congestion of the sinusoids of hepatocellular hypoxia. Pericardial effusion causes right sided heart failure and is the cause of the liver’s appearance.
The condition that could lead to the nutmeg liver appearance in the cow is pericardial effusion. This occurs due to right-sided heart failure, resulting in passive congestion of the liver’s sinusoids and hepatocellular hypoxia, causing the characteristic red and tan mottled pattern seen on necropsy.
Bovine growth hormone is also called bovine somatotropin (BST). For which approved purpose is BST sometimes given to cattle?
-Produce larger cows capable of avoiding dystocia
-Increase the rate of growth in feedlot cattle
-Prevent milk fever in dairy cattle
-Produce twinning in dairy cows
-Promote milk production
Answer: Promote milk production
Explanation
BST or rBST is given by injection to lactating dairy cows every two weeks to increase the amount of milk produced and to prolong lactation.
Bovine growth hormone, or bovine somatotropin (BST), is given to lactating dairy cows to promote milk production. It is typically administered by injection every two weeks to increase milk yield and extend the lactation period.
Bovine growth hormone is also called bovine somatotropin (BST). For which approved purpose is BST sometimes given to cattle?
-Produce larger cows capable of avoiding dystocia
-Increase the rate of growth in feedlot cattle
-Prevent milk fever in dairy cattle
-Produce twinning in dairy cows
-Promote milk production
Answer: Promote milk production
Explanation
BST or rBST is given by injection to lactating dairy cows every two weeks to increase the amount of milk produced and to prolong lactation.
Bovine growth hormone, or bovine somatotropin (BST), is given to lactating dairy cows to promote milk production. It is typically administered by injection every two weeks to increase milk yield and extend the lactation period.
You examine a 3-year old beef cow which has been acting depressed for the last 24 hours, and has failed to remain with the herd. The cow’s temperature is 104F, (40 C), heart rate is 100 bpm and is pounding loudly, and the respiratory rate is elevated at 42 breaths per minute. The mucous membranes are pale. You take a blood sample back to your nearby clinic and observe the blood smear (see image). The PCV is 20% (24-46%). Of the following, what is the single best, most cost-effective treatment for this cow?
- Long acting tetracycline injection
- Whole blood transfusion
- Procaine penicillin injection
- Vaccinate against parainfluenza-3
- Imidocarb dipropionate injection
Answer: Long acting tetracycline injection
Explanation
The blood smear shows multiple round Anaplasma marginale along the outer membrane of red blood cells.
Anaplasma marginale is an obligate intracellular bacterium. It is the most prevalent tick-borne pathogen of cattle worldwide and is endemic in tropical and sub-tropical regions. Canada is Anaplasma-free.
Infection causes large scale destruction of red blood cells and fever, weight loss, respiratory distress, abortion, and often death.
Although some cattle recover, they can become lifetime carriers as reservoirs. Anaplasma ovis can occur in sheep and goats.
Anaplasma can often be treated successfully with a single injection of long acting tetracycline (20 mg/kg).
When the PCV is below 12%, a blood transfusion may also be needed. In addition, the animal should be given ready access to feed and water.
Even with treatment, animals may remain carriers after all clinical signs resolve.
The best and most cost-effective treatment for this cow with Anaplasma marginale infection is a single injection of long-acting tetracycline (20 mg/kg). Anaplasma marginale is a tick-borne intracellular bacterium that causes red blood cell destruction, leading to fever, weight loss, respiratory distress, and anemia. A blood transfusion may be necessary if the PCV drops below 12%.
Anaplasmosis in Ruminants - Comprehensive Veterinary Information
Definitions and Terminology:
• Anaplasmosis: A tick-borne disease of ruminants caused by intracellular bacteria infecting red blood cells, leading to severe anemia and fever.
Causative Agents:
• Pathogens: Anaplasma marginale, A. centrale, A. ovis, A. phagocytophilum.
Physiopathology:
• Transmission: Ticks (Dermacentor, Rhipicephalus), mechanical via biting dipterans, contaminated needles. • Pathogenesis: Bacteria infect erythrocytes, causing their destruction by the immune system, leading to anemia and jaundice.
Clinical Findings:
• Symptoms: Progressive anemia, fever, weight loss, decreased milk production, icterus. Severe cases may lead to death.
Diagnosis:
• Tests: Blood smears (Giemsa-stain), serologic tests (ELISA), PCR. • Microscopic Findings: Anaplasma organisms in erythrocytes.
Treatment:
• Antibiotics: Tetracyclines (e.g., oxytetracycline 20 mg/kg IM), imidocarb (1.5 mg/kg SC). • Supportive Care: Blood transfusions for severely affected animals.
Control and Prevention:
• Vaccination: Use of live vaccines (e.g., A. centrale) in endemic areas. • Tick Control: Acaricides and environmental management.